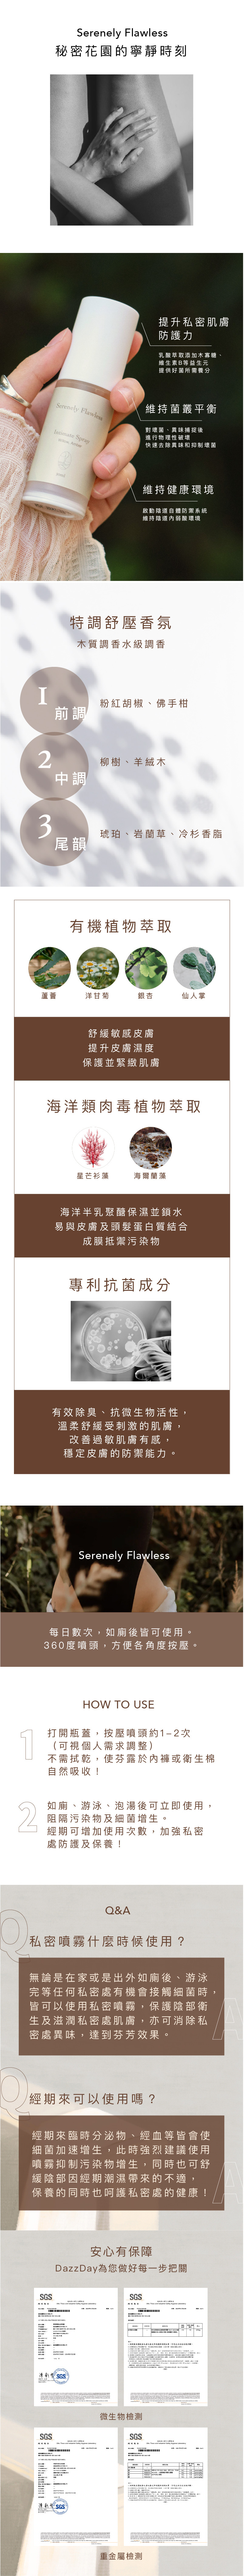
Somewhere - Intimate Spray

{{ 'fb_in_app_browser_popup.desc' | translate }} {{ 'fb_in_app_browser_popup.copy_link' | translate }}
{{ 'in_app_browser_popup.desc' | translate }}
新會員首購享95折!
全店滿1000免運
特色 | 呵護私密處芬芳的頂級保養
有感 | 乾爽淨味、溫柔呵護、去除私密處異味
成分 | 蘆薈萃取、洋甘菊提取物、仙人掌提取物、海洋類肉毒植物萃取
● 產品簡介:
中和私密處汗水、經血、分泌處等異味
● 商品規格:30ml,2瓶1組
● 保存期限:3年
● 使用方式:
1.如廁、游泳、泡澡後按壓2-3次於外陰部位,不需拭乾。
2.經期建議多加使用。
全店,全店滿1500免運(宅配/超取)
商品存貨不足,未能加入購物車
您所填寫的商品數量超過庫存
{{'products.quick_cart.out_of_number_hint'| translate}}
{{'product.preorder_limit.hint'| translate}}
每筆訂單限購 {{ product.max_order_quantity }} 件
現庫存只剩下 {{ quantityOfStock }} 件